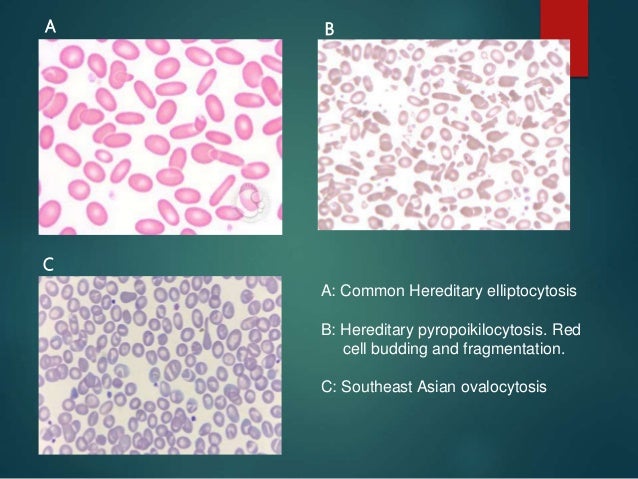
r blood factor test Osmotic membrane defects rbc & 050916 fragility r blood factor test Osmotic membrane defects rbc & 050916 fragility

36 R FACTOR BLOOD TEST
R FACTOR BLOOD TEST
Hai, thanks for visiting this amazing site to look for r factor blood test. I hope the article that appears may be beneficial to you









Osmotic fragility & rbc membrane defects 050916 , Everything You Need to Know about the C reactive Protein , Antenatal Profile Comprehensive MolQ , Find Your Lab Test Reference Lab Affiliated Medical , Wiki Medical Abbreviations , Packages , Frontiers Cardiac Morphology and Function, and Blood Gas , Packages , Food Microbiologee: Microccus & Staphylococcus , Review Article , Giant Image Management Diary of Silviamatrilineally , http://www.gogofinder.com.tw/books/pida/6/ OPTOLINK 2013 , http://www.gogofinder.com.tw/books/pida/6/ OPTOLINK 2013 , 065cih135o's Profile on Holston Multimedia Archive ,
Hai, thanks for visiting this amazing site to look for r factor blood test. I hope the article that appears may be beneficial to you

Belum ada Komentar untuk "36 R FACTOR BLOOD TEST"
Posting Komentar